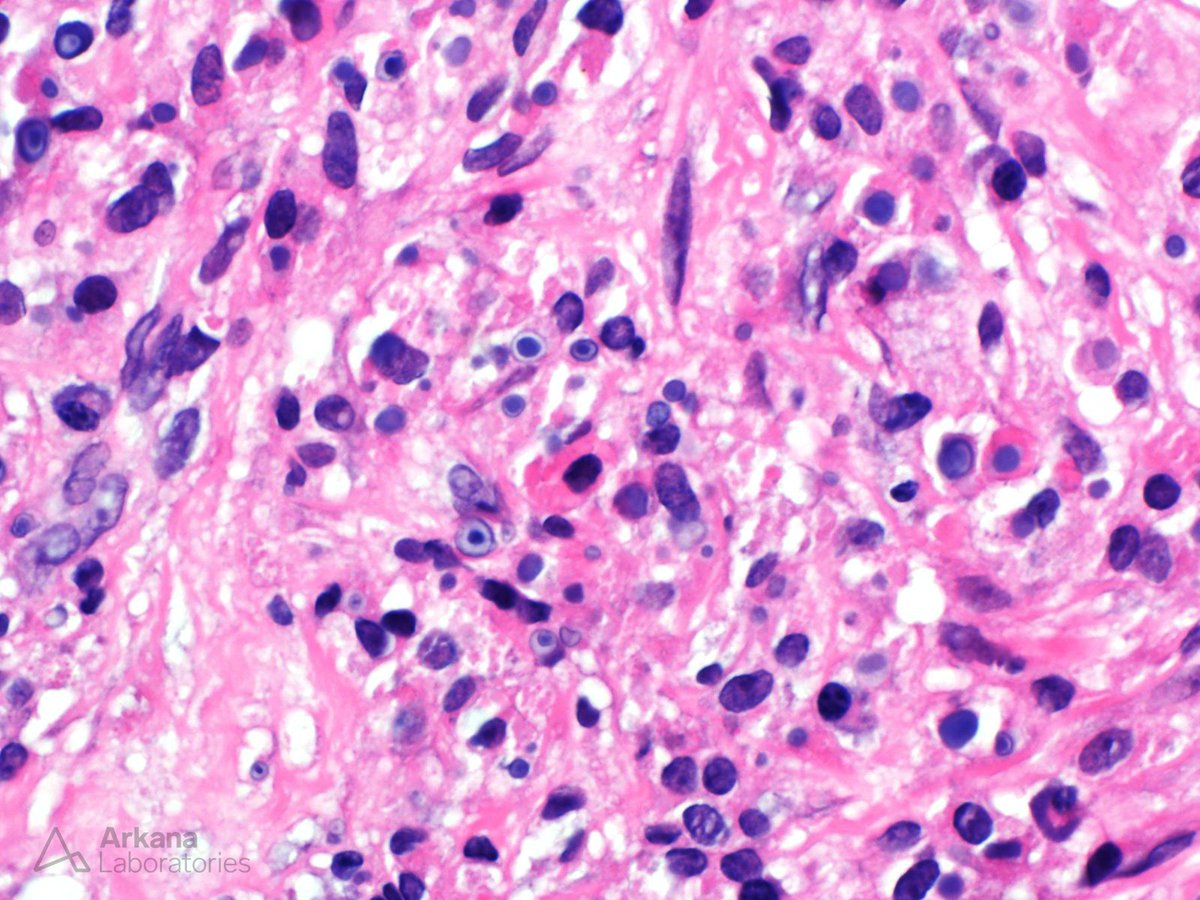
Arkana Laboratories tweet media
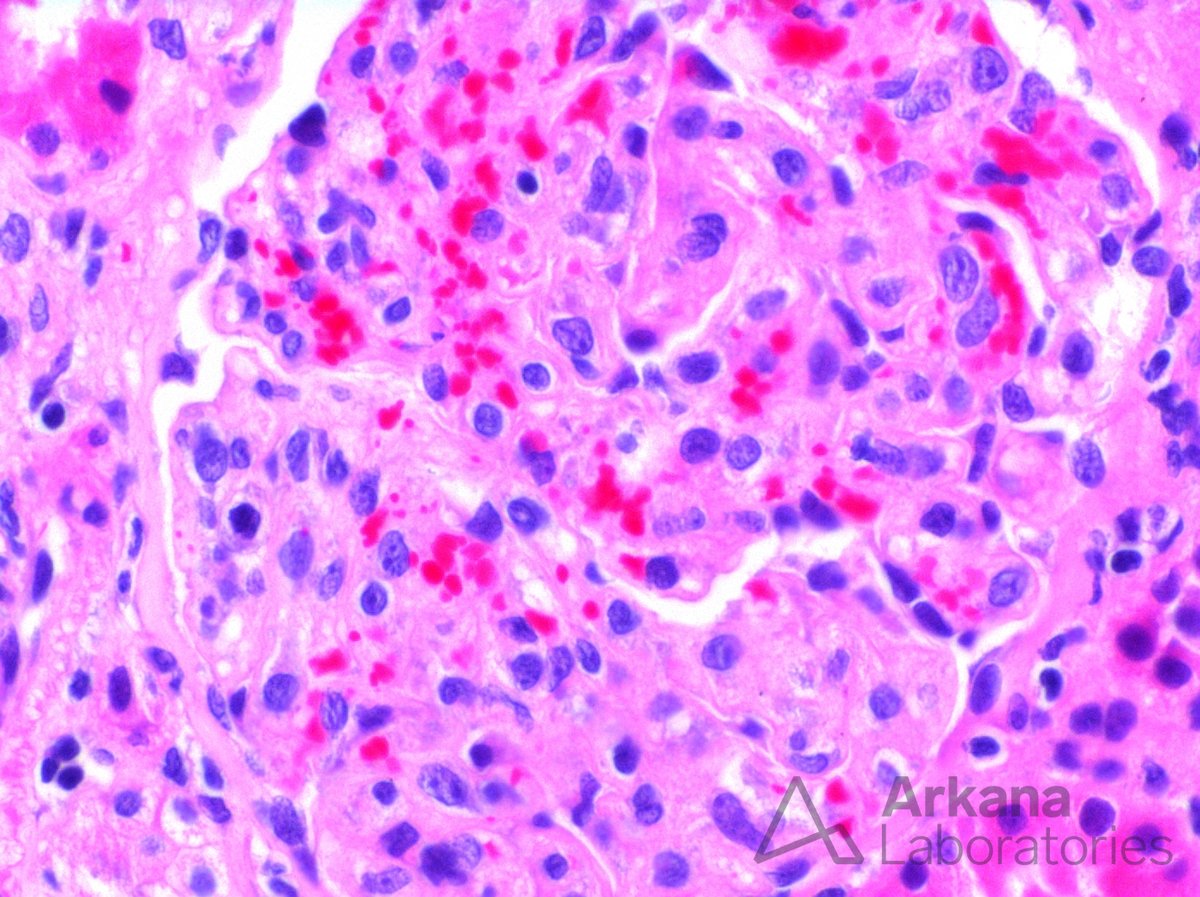
Arkana Laboratories tweet media

Emily Gardner, MD, PA(ASCP) retweetledi

Hate to be the bearer of bad news, but…
Yes, medical residents are once again exempted from being paid overtime.
See p. 378 of the final rule PDF:

Rebecca Rainey@RebeccaARainey
BREAKING: 4 million workers will now take home more money when they work more than 40 hours a week under a new Labor Dept. rule released today. The changes would make it so salaried workers earning less than about $59k annually would automatically be due overtime pay.
English